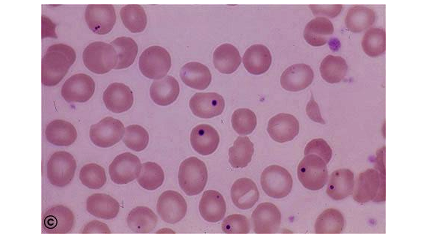

1. NGUYÊN LÝ
Trong bệnh Thalassemia, thiếu máu do rượu, thiếu máu nguyên hồng cầu khổng lồ, nhiễm độc chì hoặc arsenic có sự ngưng tập của ribosome mịn, bắt màu xanh thẫm hoặc tím, kích thước không đều trong hồng cầu trên tiêu bản nhuộm giêmsa.
2. CHỈ ĐỊNH
- Nghi ngờ bệnh Thalassemia;
- Các thiếu máu chưa rõ nguyên nhân.
3. CHỐNG CHỈ ĐỊNH
Không có chống chỉ định.
4. CHUẨN BỊ
4.1. Cán bộ thực hiện:
01 kỹ thuật viên hoặc cử nhân kỹ thuật chuyên khoa Huyết học - Truyền máu.
4.2. Phương tiện - Hóa chất
4.2.1 Dụng cụ
- Lam kính: khô, sạch, không mỡ, không mốc, không sứt mẻ;
- Lam kéo: khô, sạch, không mẻ, không xước, 2 đầu bẻ góc 2mm;
- Bút chì thường, bút chì kính;
- Bể nhuộm, giá nhuộm;
- Bàn sấy tiêu bản, máy sấy tiêu bản;
- Giá gỗ cắm đứng tiêu bản;
- Pipette Pasteur;
- Quả bóp, gạc, que thủy tinh;
- Kính hiển vi quang học.
4.2.2 Hóa chất
- Cồn tuyệt đối;
- Giemsa;
- Dung dịch pha loãng, nước trung tính hoặc nước cất.
4.3. Bệnh phẩm
- Máu tĩnh mạch chống đông bằng EDTA;
- Máu mao mạch lấy trực tiếp từ đầu ngón tay
4.4. Phiếu xét nghiệm.
5. CÁC BƯỚC TIẾN HÀNH
- Làm tiêu bản giọt đàn
- Nhuộm lam
- Nhận định kết quả
6. NHẬN ĐỊNH KẾT QUẢ
Quan sát hình thái tế bào hồng cầu (màu hồng đậm), tìm và nhận định những chấm mịn, bắt màu xanh thẫm hoặc tím, kích thước không đều (hình sau)
7. MỘT SỐ YẾU TỐ ẢNH HƯỞNG ĐẾN KẾT QUẢ
- Lam kính, lam kéo không đạt tiêu chuẩn;
- Kéo quá nhanh làm tiêu bản dày quá hoặc mỏng quá hoặc lượn sóng;
- Cồn, Giemsa không đủ tiêu chuẩn;
- Thời gian nhuộm không đảm bảo.
- Đăng nhập để gửi ý kiến

